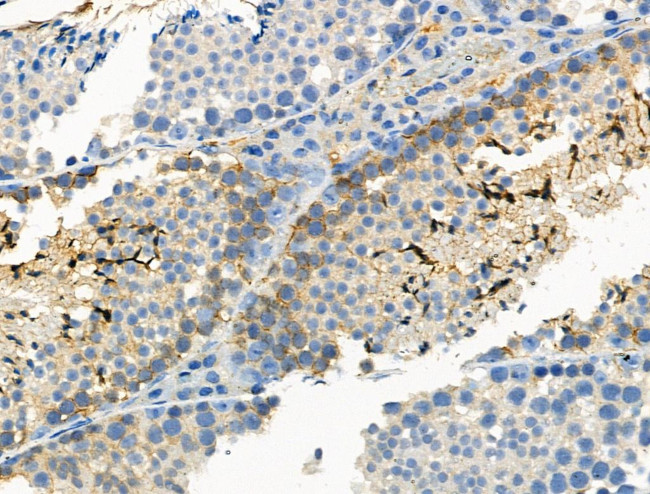
Phospho-ALK (Tyr1096) Antibody in Immunohistochemistry (Paraffin) (IHC (P))

Search
Invitrogen
Phospho-ALK (Tyr1096) Polyclonal Antibody
{{$productOrderCtrl.translations['antibody.pdp.commerceCard.promotion.promotions']}}
{{$productOrderCtrl.translations['antibody.pdp.commerceCard.promotion.viewpromo']}}
{{$productOrderCtrl.translations['antibody.pdp.commerceCard.promotion.promocode']}}: {{promo.promoCode}} {{promo.promoTitle}} {{promo.promoDescription}}. {{$productOrderCtrl.translations['antibody.pdp.commerceCard.promotion.learnmore']}}
图: 1 / 4
Phospho-ALK (Tyr1096) Antibody (PA5-105238) in IHC (P)




Please note: We are reviewing Western blot images included in the antibody testing data in our catalog, including those provided by third parties. Unless expressly labeled or annotated as “raw-unedited”, Western blot images included in the antibody testing data in our catalog may have been edited, optimized or otherwise adjusted for presentation.
产品信息
PA5-105238
种属反应
宿主/亚型
分类
类型
抗原
偶联物
形式
浓度
规格
纯化类型
保存液
内含物
保存条件
运输条件
RRID
产品详细信息
Antibody detects endogenous levels of ALK only when phosphorylated at Tyr1096.
靶标信息
Anaplastic Lymphoma Receptor Tyrosine Kinase (ALK) belongs to the insulin receptor superfamily. It is vital for brain development. Mutations, rearrangements, and amplifications in the ALK gene have been found in tumors, including anaplastic large cell lymphoma, neurblastoma, and non-small cell lung cancer. Chromosomal rearrangement is the most common genetic alteration. The translocation creates a fusion gene consisting of the ALK gene and the nucleophosmin gene: the 3' half of ALK, derived from chromosome 2, is fused to the 5' portion of NPM from chromosome 5. A recent study shows that the product of the NPM-ALK fusion gene is oncogenic. The deduced amino acid sequences reveal that ALK is a novel receptor protein-tyrosine kinase having a putative transmembrane domain and an extracellular domain. These sequences are absent in the product of the transforming NPM-ALK gene. ALK shows the greatest sequence similarity to LTK. ALK plays an important role in the development of the brain and exerts its effects on specific neurons in the nervous system.
仅用于科研。不用于诊断过程。未经明确授权不得转售。
篇参考文献 (0)
生物信息学
蛋白别名: ALK tyrosine kinase receptor; ALK/NPM1 fusion gene; Anaplastic lymphoma kinase; Anaplastic lymphoma kinase Ki1; Anaplastic Lymphoma Kinase p80; CD246; EC 2.7.10.1; kinase ALK; npm-alk; p80; TFG/ALK
基因别名: ALK; CD246; Tcrz
UniProt ID: (Mouse) P97793
Entrez Gene ID: (Mouse) 11682, (Rat) 266802